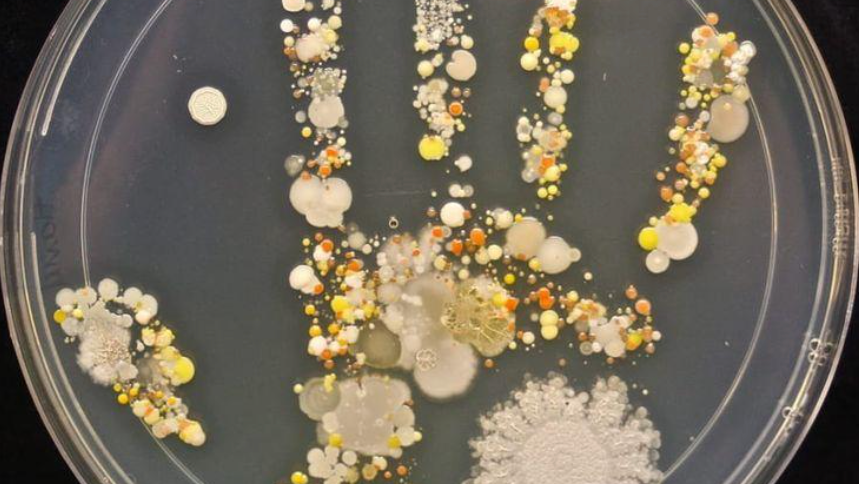
שלטון טוטליטרי

שיעור זום מיוחד לילדי ד׳–ו׳ עם הסופרת נוגה אלגום
הסופרת נוגה אלגום מזמינה ילדים בכיתות ד׳–ו׳ לשאול שאלה מסעירה – מה אנחנו באמת יודעים על החיים שלנו? ומה אנחנו אפילו לא יודעים, שאנחנו לא יודעים? בשיעור נצא למסע מרתק ומאיר עיניים על המושג ״שלטון טוטליטרי״, שבו נעבור דרך יצירות קולנוע וספרות כמו ״גברים בשחור״ ו-״שטוחלנדיה״, ונדבר גם על החיים תחת שושלת קים בצפון קוריאה.
נוגה אלגום היא סופרת ילדים, ויוצרת רב תחומית. מחזאית, תסריטאית, משוררת, מלחינה, במאית, זמרת, שחקנית ומנחה של קורסים מעוררי השראה לילדים מחוננים.
6.3 / שישי / 11:00
✱ לילדים בכיתות ד׳–ו׳
✱ משך השיעור - שעה ורבע
✱ המפגש ללא עלות. לאחר ההרשמה יישלח אליכם למייל קישור לזום.
האירוע מתקיים בתמוכת הקרן לירושלים